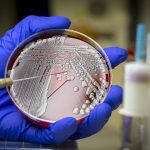
resistencia-a-antibioticos-podera-matar-mais-de-39-milhoes-ate-2050,-diz-estudo

A Agência Nacional de Vigilância Sanitária (Anvisa) publicou na segunda-feira (16) uma nota alertando sobre o risco do uso de medicamentos agonistas do GLP-1, comumente usados para tratamento de diabetes tipo 2 e obesidade, em pacientes que serão submetidos a anestesia ou sedação profunda.
É o caso de remédios como a semaglutida (Ozempic, Wegovy e Rybelsus), liraglutida (Saxenda e Victoza), liraglutida + insulina degludeca (Xultophy), lixisenatida (Soliqua), tirzepatida (Mounjaro) e dulaglutida (Trulicity).
Segundo a Anvisa, esses medicamentos aumentam o risco de aspiração e pneumonia em procedimentos de anestesia e sedação profunda, devido à sua ação no retardamento do esvaziamento gástrico. Essas complicações podem ser causadas pela inalação acidental de alimentos ou líquidos para uma via respiratória ou podem, ainda, ocorrer quando o conteúdo do estômago volta para a garganta (refluxo).
Diante disso, a agência recomenda que profissionais de saúde questionem os pacientes que serão submetidos às cirurgias com anestesia ou sedação profunda sobre o uso desse tipo de medicamento. Além disso, a Anvisa recomenda a adoção de medidas para garantir a ausência do conteúdo gástrico residual antes da realização de procedimentos anestésicos.
Da mesma forma, os pacientes devem fornecer ao profissional de saúde informações sobre o uso de tais medicamentos, caso tenham uma cirurgia planejada.
Ozempic e Wegovy podem reduzir risco de câncer, segundo estudo

Deixe um comentário